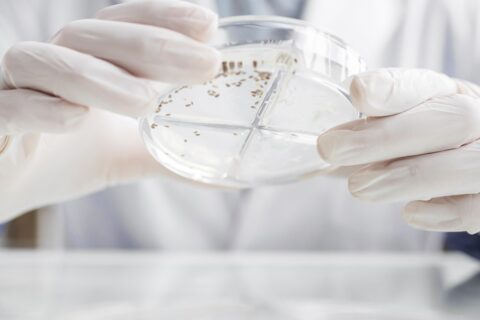

We are thrilled to offer our cheap replica watches expertise and support to lesbian couples seeking to start a family. Our replica omega expert care, supportive attitude and compassionate care make the journey to parenthood both medically and legally sound and fake rolex straightforward.
IVF for lesbian couples
IVF for lesbian couples
Our Donor IUI service is led by doctors
Whilst the IUI (using donor sperm) treatment is very straight forward, there are nuances which are best handled by experienced clinicians. At Acorn Fertility, from the first consultation to the final IUI, the treatment is led by experienced doctors.
IUI with Donor Sperm
For most lesbian couples, the primary (and only) challenge is the absence of sperm. The “fertility apparatus” (uterus, Fallopian tubes and ovaries) are normal, so a simple Intra-Uterine insemination of donor sperm is enough to achieve pregnancy.
We provide access to high-quality donor sperm from reputable sperm banks, allowing you to choose donors based on desired characteristics such as ethnicity, physical appearance, and more. Our team is always at hand to help you understand the nuances of the sperm selection process, so you can choose confidently.

A Complete Package
We offer comprehensive treatment packages, including up to three cycles of intrauterine insemination (IUI), coupled with counseling and legal advice to make the process seamless and stress-free.
Our pricing page details some of the most competitive IUI/DI packages in the UK, with treatment starting at just £1150 per cycle (plus the cost of sperm and medications).
Our 3 cycle package is even more competitive – only £2800 for 3 cycles of IUI.
Personalized Support
Our dedicated team provides personalized support throughout your fertility journey. From initial consultation to post-treatment care, we are here to guide you every step of the way, ensuring you feel informed and comfortable with your choices. Apart from experienced nurses and embryologists, our senior doctors take all decisions from the timing of the trigger and perform or atleast supervise all scans and the actual IUI procedure.
Legal and Emotional Guidance
Navigating the legal aspects of using donor sperm can be complex. Our experienced counselors offer guidance on legal matters and emotional support, helping you make well-informed decisions with confidence.
Steps in the treatment
- Initial Consultation and discussion about treatment
- Arranging various Tests required by the HFEA (infection screening)
- Checking tubal patency
- Counselling with a trained counsellor
- Providing medications for ovarian stimulation (if required) and trigger injection
- Monitoring scans from the 9th day of your period
- Triggering ovulation when the follicles are ready
- Actual IUI, to match the timing of ovulation.

Frequently Asked Questions (FAQ's)
Find answers to your fertility questions. The following provides information on the different types of fertility treatments, as well as common reasons for infertility.
What is the process of having treatment with donor sperm?
The first stage is to come into the clinic for an Initial Consultation. This will include an internal scan for the female undergoing the treatment and a consultation with the doctor for her (and her partner if applicable). This appointment allows the doctor to assess the ovaries and womb and determine the best course of treatment. The next stage will be to meet with a nurse at the nurse’s consultation. At this point the patient(s) can discuss which donor sperm is to be used and the nurse can go through our list of sperm donors with you. If you decide to purchase sperm from an external sperm bank this is perfectly fine; however you will have to arrange for the sperm to be couriered to the clinic. The treatment itself is exactly like our other types of IVF: the female patient will take a suitable combination of drugs for several days before having her eggs collected under sedation. These will then be fertilised with the donor sperm in the lab before being transferred to the woman’s womb a few days later.
If you plan to use a known donor, he will need to go through a series of stages to assess his suitability. It is best to contact us for more details on using a known donor.
Who is this treatment suitable for?
IVF treatment with donor sperm is most suitable for couples with a male infertility factor, female same-sex couples and single women.
What is Mild IVF?
Mild IVF focusses on quality rather than quantity of eggs, is conducted within a woman’s natural cycle and uses lower doses of stimulating drugs. Mild IVF uses a short 7-10 day course of stimulating drugs to achieve a mild response.
Mild IVF is designed to be gentler on the body with fewer side effects. The short protocols with lower doses of drugs mean that the stress and duration of treatment and potential side effects are reduced.
What is the Intra-Uterine Insemination (IUI) process?
The first step in IUI treatment is to come into the clinic for an Initial Consultation and Scan. At this point the doctor will perform an internal scan. You (and your partner if applicable) will then have a 30 minute consultation where the doctor will go through your medical history and devise a personalised treatment plan. It is recommended that you undergo a tubal patency test in order to ensure that your fallopian tubes are clear and the sperm is able to reach the egg. You will then come in for a number of scans following the start of your period. These will be used to monitor the growth of the follicles and track ovulation. Once the time is right to perform the IUI, the sperm sample will be washed and prepared before the procedure. The IUI procedure involves introducing the sperm to the uterus through a thin catheter at the correct time of the cycle when the egg is being released.
Other Services
Since its founding Acorn Fertility has been providing its patients with full medical care, encompassing
outpatients services, laboratory and imaging diagnostics, dentistry and immediate care.
IVF
Once considered a revolutionary treatment for infertility, IVF is now commonplace and helps…
Oocyte Freezing
In the last ten years, egg freezing (oocyte cryopreservation) has come of age…
Mild Stimulation IVF
Mild Stimulation IVF Treatment can reduce the risk of women’s medication for Ovarian…
Get Free Initial Telephonic Consultation, Call +44 20 7569 3000
Fees are an estimate only and may be more depending on your situation
- GET FREE TELEPHONIC CONSULTATION